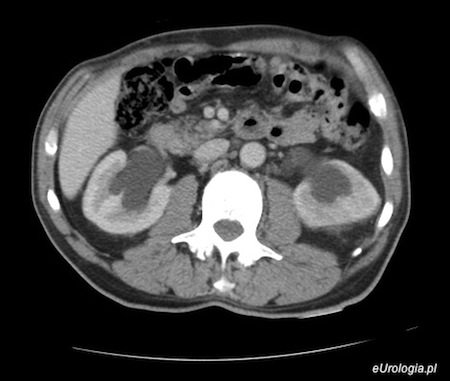
Wodonercze obustronne - obraz w tomografii komputerowej.

Wodonercze obustronne
Dwa dni temu mój mąż trafił do szpitala z powodu osłabienia, duszności i zmniejszenia ilości oddawanego moczu. Od kilku lat mąż choruje na raka gruczołu krokowego. W czasie diagnostyki lekarze stwierdzili u męża obustronne wodonercze. Wodonercze rzekomo spowodowane jest chorobą nowotworową prostaty. Jak wygląda leczenie wodonercza obustronnego? Kreatynina w tej chwili wynosi 4. Czekamy na konsultację urologiczną.
Odpowiedź zespołu eUrologia.pl
Wodonoercze obustronne w przebiegu raka gruczołu krokowego, jakie zostało rozpoznane u Pani męża wymaga leczenia objawowego. Jeśli pacjent się zgadza możliwe będzie założenie nefrostomii - przezskórnego drenażu założonego do nerki, który umożliwi swobodny odpływ moczu z nerki. W razie potrzeby konieczne będzie rozszerzenie diagnostyki, która pozwoli ocenić czy rzeczywiście pozanerkowa niewydolność nerek jest wynikiem raka gruczołu krokowego.
Fot. Wodonercze obustronne - obraz w CT jamy brzusznej
Polecane artykuły
Wodonercze - informacje ogólne
Założenie nefrostomii - opis zabiegu
Rak prostaty